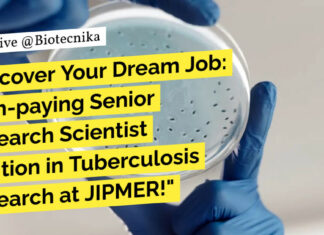
Earn Rs. 1.25 Lakh pm as Senior Research Scientist at JIPMER! Microbiology Apply JIPMER PhD Microbiology Research Job - Apply For Scientist Role

Clinical Data Quality Job at Merck Group! Life Sciences Apply Now
Clinical Data Quality Job at Merck Group! Life Sciences Apply Now
Title: DMCQ-0, Specialist, Clinical Data Quality
Location: Bangalore – Electronic City
SCOPE OF RESPONSIBILITY:
Scope of an...
Tata Memorial Centre-ACTREC Life Science Junior Research Fellow Position Available
TMC-ACTREC JRF Position Available For Life Science
TATA MEMORIAL CENTRE
ADVANCED CENTRE FOR TREATMENT, RESEARCH AND EDUCATION IN CANCER
Kharghar, Navi Mumbai- 410 210
www.actrec.gov.in
Phone No: 91-22-27405000, Extn.:5353/5082
(A...
Beckman Coulter Life Sciences Scientist-I Projects Vacancy For Biotech & Biochem...
Beckman Coulter Project Scientist Job For Biotech & Biochem, Apply Online
Scientist-I Projects
Beckman Coulter Life Sciences
Bangalore, Karnataka, India
Category: Engineering
Job Id: R1272103
Location: Bangalore, Karnataka, India
We are...
ARI Pune PhD Admissions 2024 – Applications Invited Online
ARI Pune PhD Admissions 2024 - Applications Invited Online
Advt. No. ARI/PhD/2024/01
Ph.D. Admissions - 2024
Last date for receipt of online applications: 29th August 2024
Agharkar Research...
Earn Rs. 1.25 Lakh pm as Senior Research Scientist at JIPMER!...
JIPMER PhD Microbiology Research Job - Apply For Scientist Role
JIPMER PhD Microbiology Research Job - Apply For Scientist Role. Interested and eligible applicants can...
Dream Job Alert at IISER Thiruvananthapuram – Make Rs. 56000+HRA!
IISER TVM PhD Research Project Personnel Recruitment For Life Sciences
INDIAN INSTITUTE OF SCIENCE EDUCATION AND RESEARCH THIRUVANANTHAPURAM
Recruitment of Research Project Personnel
The Indian Institute of...
ICGEB Hiring BTech, MTech & MSc Life Sciences – JRF...
ICGEB Life Science Vacancies For BTech, MTech & MSc - Apply Now
VACANCY NOTICE
JRF POSITION AVAILABLE
One Junior Research Fellow (JRF) Position is available in the...
CSIR-IGIB PhD Program January 2025 – Online Application Process
CSIR-IGIB PhD 2025 Program - Online Application Process
CSIR-IGIB PhD Program 2025 - Online Application Process. CSIR-IGIB PhD Program 2025 - Online Application Process PhD...
CSIR-CCMB January 2025 PhD Program Admission – Online Application Process
CCMB 2025 PhD Admissions January Session - Online Application Process
CCMB 2025 PhD Admissions January Session - Online Application Process. CSIR-CCMB PhD 2025 Admission. Application...
The Pivotal Role of Bioinformatics in Biotech Career – Must Read
Role of Bioinformatics in Biotechnology Career
Science and technology have evolved as a result of the integration of bioinformatics and biotechnology. The importance of bioinformatics...
Applications Invited For Life Science Postdoctoral Fellow Post at Institute of...
Life Science Postdoctoral Fellow at Institute of Health Sciences, Presidency University
Advertisement Inviting Applications for the Position of Postdoctoral Fellow in DBT/Wellcome Trust India Alliance...
Govt K-SAP Official Notification – Karnataka Startup Advancement Programme 2024 –...
Karnataka Startup Advancement Programme, K-SAP
Applications Open
Advancement programmes are instrumental in guiding startups through various stages of growth within entrepreneurial ecosystems. These programmes offer a...
BRIC-NIPGR Latest Recruitment | Project Scientist & Associate Post – Salary...
BRIC-NIPGR Latest Recruitment
BRIC-National Institute of Plant Genome Research
(An Autonomous Research Institution of the Department of Biotechnology Ministry of Science and Technology, Govt. of India)
Aruna...
Expected Cut Off & Complete Analysis of CSIR NET Life Science...
Analysis of CSIR NET July 2024 Question Paper
The Question Paper and Answer Key of CSIR NET Life Science July 2024 were released last week....
Msc / Mtech Freshers Excellent Opportunity To Work at DBT-Centre for...
Bioinformatics Freshers Job
The DBT-Centre for Microbial Informatics at the University of Hyderabad is inviting applications from eligible Indian nationals for the position of Project...